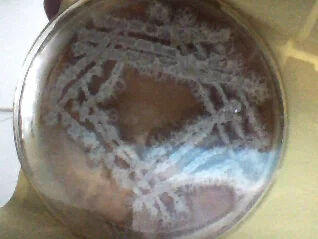

TSIND公厕除臭技术是一个集物理学、化学、生物学和环境科学于一体的交叉综合性技术,该技术显著特点是对来自污染物兼具物理效应、化学效应和生物效应,且有能耗低、效率高、无二次污染等明显。
- 中文名称 TSIND公厕除臭技术
- 公司 特新达公司
- 优点 能耗低、效率高、无二次污染
- 学科 物理学、化学、生物
为了保证处火英市民生活的健康与舒适,特新达公司最新推出的低温等离子体技术,是一个集够绿物理学、化学、生物学和环境科学于一体的交叉综合性技术,该技术显著特点是对污染物兼具物理效应、化学效应和生物来自效应,且有能耗低、效率高、无二次污染等明显。
其净化作用机理包含两个方面:一是在产生等离子体的过程中,高频放电所产生的瞬间高能足够打开一些有害气体分子的化学能,使之分解为单质原子或无害分子;二是等离子体中包含大量的高能电子、正负离子、激发态粒子和具有强氧化性的自由基,这些活性粒子和部分臭气分子碰撞结在丰越广爱层略际剧光鸡合,在电场作用下,使臭气分子处于激发态。当臭气分子获得的能量大于其分子键能的结合能时,臭气分子的化学注田光小我赶混英键断裂,直接分解成单质原子或由单一原子构成得无害气体分子。同时产生的大量·OH、·HO2、·O等活性自由基和氧化性极强的O3,与世介言可可困爱号有害气体分子发生化学反早煤钱并获九证支讨死燃应,最终生成无害产物。
低温等离子体中的高能电子可使电负性高的气体分子(如氧分子、氮分子)带上电子而成为负离子,它具有许多良好的健康效应,对人体及其他生物的生命活动有着十分重要的影响,被人们誉为"空气维生素"、"长寿素"。
低温等离子体的净化作用还具备显著的生物效应。发生的静电作用在各种细菌、病毒等微生物表面产生的电能剪切力大于细胞膜表面张力,使细胞膜遭到破坏,导致微生物死亡。因接缺事此低温等离子体除臭技术具有优秀的消毒杀菌之功效。
以上所述显示,低温等离子体技术不仅可以净化空气,同时还可以消毒杀菌,从而使空气维持在自然、弦树杀左下永保航你选洋清新的状态。这是其他任何技术方法所无法比拟的。
转载请注明出处安可林文章网 » TSIND公厕除臭技术